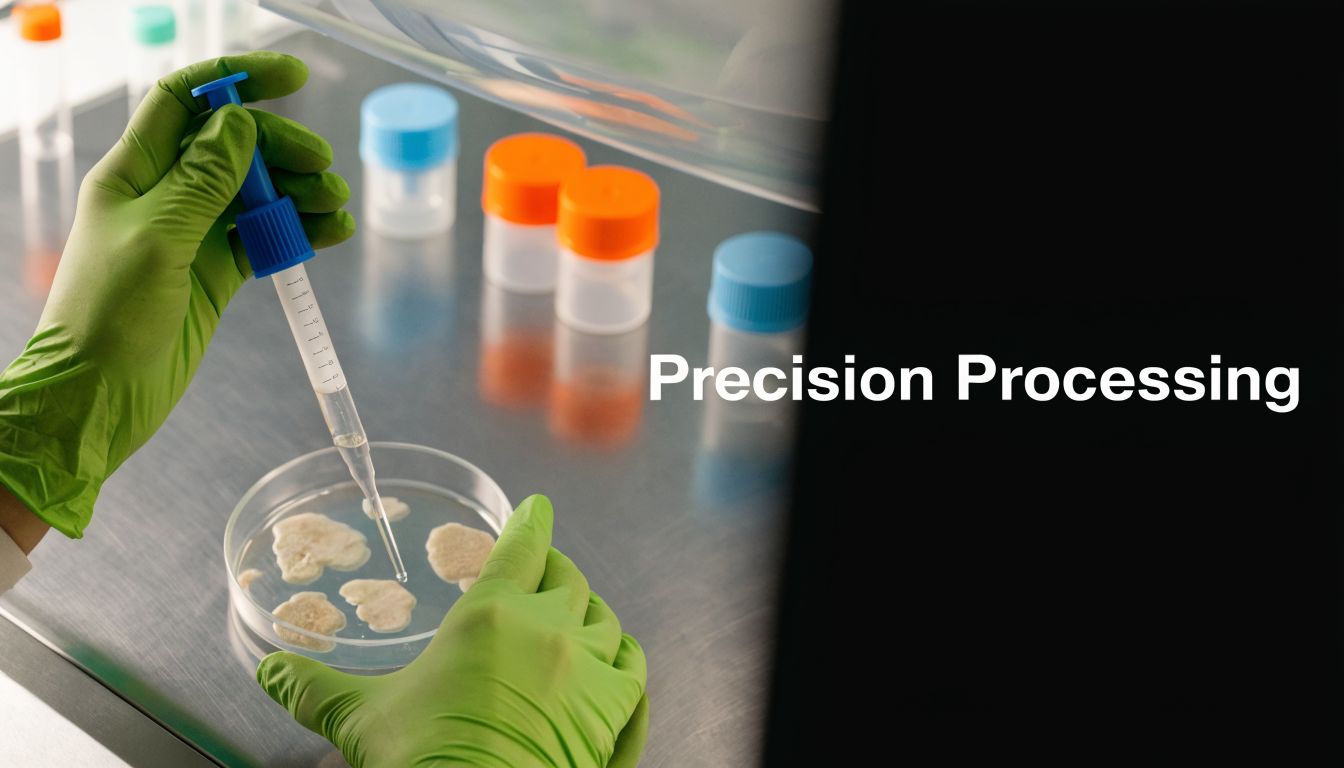
A laboratory scientist wearing green gloves uses a pipette to process biological samples in a petri dish.

Autologous Versus Allogeneic: Stem Cell Therapy Explained
Many people begin their search for regenerative care with a simple assumption: using your own cells must always be better than using donor cells. It sounds intuitive. Your body knows your body, so why look elsewhere?
In practice, the decision is more nuanced. In regenerative medicine for joints, soft tissue, inflammation, recovery, and healthy aging, the better question is often this: which cell source gives the right balance of safety, consistency, potency, and practicality for your biology today? For a younger person with ample tissue reserves, that answer may look different than it does for someone managing chronic inflammation, metabolic stress, orthopedic degeneration, or age-related cellular decline.
Patients also get mixed messages because much of the public conversation around autologous versus allogeneic therapy comes from cancer medicine, where the rules, risks, and goals are very different from orthopedic and longevity-focused care. That leaves many people asking the question that matters most to them: Are my own older cells stronger because they’re mine, or are carefully prepared donor cells better because they’re younger and more consistent?
That’s the right question.
The answer starts with understanding what these two terms mean, why the immune system matters, and why cell quality can be just as important as cell origin. If you're exploring regenerative options, cell regeneration therapy only makes sense when the biology is transparent and the trade-offs are clearly explained.
Choosing Your Path to Cellular Regeneration

Healing with cells isn't a single category of treatment. It’s a family of approaches built around one central choice: do we work with cells taken from you, or cells provided from a donor source?
That choice shapes everything that follows. It affects how the cells are collected, how they’re processed, how long the treatment pathway takes, what the body may recognize as familiar or foreign, and how much consistency a clinician can expect from one patient to the next.
The question most patients are really asking
Learning vocabulary for its own sake is not the primary aim; practical guidance is sought.
They want to know:
- Will my body respond better to my own cells
- Does age reduce the strength of autologous cells
- Are donor cells safe in regenerative medicine
- Is one option more convenient or more predictable
- Which approach makes more sense for chronic pain, joint wear, sports injury, or inflammation
These are reasonable concerns. They also deserve plain answers, not marketing slogans.
Why this choice isn’t purely philosophical
Think of regenerative medicine like restoring a damaged garden. Sometimes the best solution is to replant with seeds from your own healthiest plants. Other times, the original plants have been exposed to years of drought, disease, or poor soil, and the more strategic option is to introduce carefully selected healthy material from a strong outside source.
Both ideas can make sense. The right fit depends on the condition of the garden.
Practical rule: In autologous versus allogeneic decisions, “natural” isn’t the only standard. Clinicians also have to weigh cell vitality, immune behavior, processing quality, and the goals of treatment.
For people seeking regenerative care in orthopedics, wellness, or longevity medicine, this isn’t only about whether cells are “self” or “donor.” It’s about whether the chosen cells can support a meaningful biological response in tissue that may already be stressed by time, inflammation, or degeneration.
That’s where a careful comparison becomes useful.
The Source of Healing Core Biological Differences
Autologous means the cells come from the same patient who receives them. Allogeneic means the cells come from a donor.
Those definitions sound simple, but they carry major biological consequences.

Self versus donor in everyday language
A useful analogy is home repair.
Autologous therapy is like renovating your house using materials already on your property. The match is natural because it’s yours. But if the available materials are old, weathered, or limited, the final result may depend on what quality remains.
Allogeneic therapy is like bringing in carefully selected new materials from an outside supplier. That can offer freshness, consistency, and readiness. But because the materials didn’t originate in your home, compatibility and oversight matter far more.
This is the center of the autologous versus allogeneic discussion.
Why the immune system changes the conversation
Your immune system is designed to distinguish self from non-self. That’s a protective feature. It helps defend you from infection and other threats. It also means that donor-derived therapies require closer thought because the body may react differently to something it didn’t generate.
That principle is well established in transplantation medicine. In a meta-analysis published in JAMA Network Open, autologous hematopoietic stem cell transplantation showed 3-year transplant-related mortality of 7%, while allogeneic transplantation showed 32%. Those numbers come from a transplant setting, not from routine orthopedic or wellness applications, but they clearly illustrate the immune burden that donor cells can create when the therapeutic context carries strong rejection risk.
The same analysis reported 3-year overall survival of 55% for autologous transplantation and 50% for allogeneic transplantation, with 3-year progression-free survival of 41% and 42% respectively. The key lesson for regenerative readers is not that these exact outcomes apply to joint or longevity care. They don’t. The lesson is that cell origin affects immune risk, and that difference matters whenever clinicians assess donor-based therapy.
Where patients often get confused
Patients often hear two statements that seem to conflict:
- Your own cells are safer because they’re recognized as self
- Donor cells can be stronger because they may come from healthier, more biologically active sources
Both can be true.
Autologous approaches reduce classic rejection concerns because the cells come from the same body. Allogeneic approaches may offer practical and biological advantages, but they demand careful source selection and processing.
For readers who want a broader foundation in stem cell biology, multipotent versus pluripotent stem cells is another distinction worth understanding because not all cell types behave the same way or carry the same therapeutic implications.
The first decision in cell therapy isn’t “Which clinic?” It’s “What kind of biology am I putting into my body, and why?”
That question leads directly into the practical differences that matter most in regenerative medicine.
A Practical Comparison for Regenerative Medicine
In regenerative care, patients rarely compare therapies in abstract terms. They compare them by what they’ll experience. How many steps are involved? How long does it take? How much confidence can a physician have in the material being used? And for someone in their fifties, sixties, or beyond, does “my own cells” always mean “my best cells”?
Those are the practical issues behind autologous versus allogeneic treatment choices.
Autologous versus allogeneic at a glance
| Criteria | Autologous Therapy (Patient's Own Cells) | Allogeneic Therapy (Donor Cells) |
|---|---|---|
| Cell source | Collected from the patient | Collected from a donor |
| Immune familiarity | Naturally recognized as self | Requires careful biological and clinical consideration |
| Procedure flow | Usually includes a harvest step, processing, then treatment | Often designed for ready availability |
| Cell consistency | Can vary from patient to patient | Can be standardized more tightly in controlled production |
| Effect of age and health | May reflect the patient’s age, inflammation, and tissue history | May draw from healthier donor sources selected for quality |
| Scalability | Personalized and less scalable | Better suited to larger-scale manufacturing |
| Clinical appeal in regenerative settings | Familiar biology, but variable source quality | Consistency and convenience, with quality control becoming central |
Potency matters more than many people realize
A younger, healthier donor source may offer a practical advantage in regenerative medicine because the cells don’t carry the same personal history of aging, chronic inflammation, or metabolic strain that many patients bring to treatment.
That doesn’t mean autologous cells are without value. It means they aren’t automatically ideal solely because they originated in the same body. A sixty-year-old knee with chronic wear doesn’t exist in isolation from the rest of the body’s biology. If the source cells come from a system shaped by age, inflammatory burden, or lower regenerative reserve, their performance may be less predictable.
Standardization changes the patient experience
One of the strongest operational arguments for donor-based treatment is manufacturing consistency. As described by Genedata’s discussion of autologous and allogeneic cell therapies, allogeneic approaches allow manufacturers to produce standardized, high-quality cells for many patients from a single donor source, while autologous approaches involve patient-specific manufacturing and greater variability in cell quality.
That has direct practical consequences:
- Scheduling is simpler because treatment doesn’t always depend on collecting and preparing your own material first.
- Quality control can be tighter because the production pathway can be repeated and monitored in a more uniform way.
- The patient experience is often lighter because there may be no harvest procedure before the main treatment.
- Clinical planning is cleaner because physicians know more about the incoming product before treatment day.
Procedure burden is different
Autologous care often requires a sequence. First, cells are collected. Then they’re processed. Then the patient returns for administration. Some patients accept that pathway easily. Others don’t want an additional invasive collection step, especially if they’re already dealing with pain, mobility loss, or fatigue.
Allogeneic care can feel simpler because the therapeutic material may already be prepared in advance under controlled conditions. For an active adult traveling for care, that difference can matter.
For many orthopedic and longevity patients, the practical burden of treatment matters almost as much as the biological theory behind it.
Which patients tend to ask about this most
The same questions come up again and again in consultation settings:
- Active adults with joint degeneration who wonder whether their own cells still have enough vitality
- Athletes recovering from injury who want a therapy that fits a narrow recovery window
- People with chronic inflammation who worry that their internal environment may not be an ideal source material
- Medical travelers who need efficiency, clarity, and fewer procedural steps
For these patients, allogeneic therapy often enters the conversation not because it sounds futuristic, but because it may offer a more controlled starting point.
A separate but related comparison many patients explore is exosomes versus stem cells, since both are discussed in regenerative care but work through different biological mechanisms.
The central trade-off
Autologous therapy offers familiarity. Allogeneic therapy offers consistency and scalability.
The most useful question isn’t which concept sounds more appealing. It’s which option fits the patient’s age, tissue condition, inflammatory state, timeline, and treatment goals.
That’s why a thoughtful clinic won’t reduce this decision to “your cells good, donor cells bad,” or the reverse. The quality of the source and the rigor of the process are what make the comparison meaningful.
Evaluating Safety Efficacy and Clinical Evidence
Safety is where this conversation has to be honest.
If someone tells you donor-based therapy has no immune considerations at all, that’s too simplistic. If someone tells you donor-based therapy is always unsafe in every setting, that’s also too simplistic. The truth sits in the biology, the cell type, and the way the therapy is prepared.
What the transplant data teaches, and what it doesn’t
In transplant medicine, immune complications can be profound. A systematic review and meta-analysis available through PubMed Central reported 3-year transplant-related mortality of 7% with autologous transplantation and 32% with allogeneic transplantation, and in the AATT trial discussed in that review, eight patients in the allogeneic group died from treatment-related complications versus zero in the autologous group.
Those are serious figures. They should never be ignored.
But context matters. These findings come from hematopoietic stem cell transplantation in disease settings where donor immune effects, conditioning regimens, and graft-versus-host dynamics are central to treatment. That is very different from modern regenerative protocols using carefully selected cell types for chronic pain, orthopedic support, or inflammation-focused care.
Why regenerative medicine uses a different lens
Regenerative applications are typically not trying to replace the entire marrow or re-engineer the immune system in the same way transplant oncology does. The relevant question becomes whether the selected donor-derived cells are suitable for regenerative use and whether the manufacturing pathway minimizes avoidable risk.
That’s why clinical judgment has to focus on:
- Cell type
- Donor screening
- Processing standards
- Route of administration
- Patient selection
When these pieces are handled carefully, the risk conversation becomes more precise and more useful.
The evidence gap patients should know about
For orthopedic and degenerative uses, patients often want a head-to-head answer: Which is better long term, autologous or allogeneic? The honest answer is that the evidence remains incomplete.
The underserved angle identified by AVS Life Sciences in its discussion of autologous versus allogeneic stem cell therapies is exactly this gap. Existing content tends to focus heavily on rejection risk and cancer applications, while longitudinal comparisons in orthopedic and sports injury settings remain limited. That source notes a review finding inconclusive therapeutic benefits between autologous and allogeneic mesenchymal stem cells for degenerative conditions, with no significant differences in pain relief or function at 12 to 24 months in small trials, and it also highlights that patients commonly ask whether their own older cells may underperform compared with younger donor-derived options.
That’s a fair question. It deserves a careful, individualized answer rather than a slogan.
Clinical perspective: In regenerative medicine, “safe” doesn’t mean “simple.” It means the cell source, lab process, and patient selection all match the biology of the condition being treated.
How to read efficacy claims wisely
Patients should be cautious with bold promises. In this field, good decision-making depends less on dramatic claims and more on sober interpretation.
A stronger way to evaluate a therapy is to ask:
- What kind of cells are being used
- How are donors screened
- How are the cells processed and quality checked
- Is the clinic transparent about what is known and what is still emerging
- Does the team discuss limitations, not only upsides
If you want a deeper look at how safety questions are interpreted through published data, our published research conclusions on stem cell safety provide useful context.
The most trustworthy regenerative conversations don’t erase uncertainty. They explain it clearly, then narrow risk through careful protocols.
The Critical Role of Lab Processing and Quality Control
For donor-based therapy, the lab is not a background detail. It is part of the treatment.
A patient may focus on the injection, the IV, or the consultation, but much of the critical safety work happens earlier. It happens when donor material is evaluated, when cells are processed, when batches are checked, and when release standards determine whether a product should ever reach a treatment room.
Why quality control changes everything
In autologous therapy, one major variable is the patient’s own source material. In allogeneic therapy, one major variable is lab discipline.
A high-integrity lab pathway should address several checkpoints:
- Donor screening: The donor source must be evaluated carefully before any cells enter processing.
- Controlled cultivation: Cells need to be handled under strict conditions designed to preserve quality and reduce avoidable contamination risk.
- Batch consistency: The team should know whether the final product behaves consistently from lot to lot.
- Release criteria: Not every processed sample should automatically be used. Products need standards for acceptance.
- Traceability: A clinic should be able to track what was prepared, from whom, and under what conditions.
Without those steps, “allogeneic” is just a label. With them, it becomes a clinically structured product category.
Why source type matters in modern regenerative care
Not all donor-derived cells come from the same tissue source, and that matters for both biological behavior and therapeutic intent. In premium regenerative settings, clinicians may work with multiple allogeneic cell types depending on the treatment goal.
At Longevity Medical Institute, the in-house biotechnology platform produces five different types of stem cells, including placental, Wharton’s jelly, adipose, endometrial, and dental pulp sources. That kind of source diversity matters because different tissues may be selected for different regenerative contexts rather than treated as interchangeable materials.
Patients looking into a biotechnology stem cell lab in Mexico should pay attention to whether the clinic controls production or receives outside products with limited transparency.
What certifications mean in practical terms
Terms like COFEPRIS-licensed and ISO-certified can sound administrative, but for patients they signal something more important: a repeatable system.
A meaningful lab environment is one where protocols aren’t improvised. Documentation matters. Handling standards matter. Environmental control matters. The difference between a polished website and a reliable laboratory is the presence of disciplined process.
This short video gives useful visual context for how patients can think about the lab side of regenerative medicine:
The more allogeneic therapy depends on donor material, the more patients should care about who screened it, who processed it, and who decided it was fit for use.
A better question than self versus donor
Patients often ask, “Should I trust my own cells or donor cells more?” A better question is, which source is being prepared under conditions that make it biologically credible and clinically responsible?
That shifts the conversation from ideology to process.
And in regenerative medicine, process often determines whether a promising idea remains theoretical or becomes a treatment pathway worth considering.
Making Your Decision with Longevity Medical Institute
By the time people understand autologous versus allogeneic therapy clearly, the decision usually becomes less emotional and more strategic.
Autologous therapy has an understandable appeal. It uses your own cells. It avoids the intuitive discomfort some people feel about donor material. In certain contexts, that can be a legitimate reason to consider it.
But regenerative medicine for chronic pain, orthopedic wear, inflammation, and healthy aging raises a harder question. If the body you’re trying to help has been shaped by age, stress, degeneration, or systemic inflammation, do you always want the therapeutic material to come from that same environment?
Why many patients lean toward donor-derived care
For many adults seeking regenerative treatment, the appeal of allogeneic therapy comes down to three ideas:
- Consistency: The source can be selected and processed under controlled conditions.
- Readiness: Treatment may not require a separate harvest procedure first.
- Cellular freshness: Donor-derived material may avoid some of the age-related limitations that concern patients using their own cells.
That doesn’t make donor-based treatment universally superior. It means the rationale is clinically coherent, especially in the settings where patients often travel for care.
The role of individualized judgment
A thoughtful physician doesn’t choose a cell source based on fashion. The decision should reflect the condition being treated, the patient’s medical profile, the intended route of administration, and the quality systems behind the product.
For someone with a focal orthopedic problem and strong biological reserve, an autologous discussion may still be relevant in the broader field. For someone seeking a more standardized regenerative strategy, particularly in the setting of age-related decline or multi-site inflammation, allogeneic care often makes practical and biological sense.
Why specialization matters
Many clinics present every option as equally ideal. That can sound flexible, but it isn’t always clarifying.
A more disciplined model is to specialize in the pathway a clinic can support with clear sourcing, rigorous processing, and coherent clinical reasoning. When a center focuses on allogeneic regenerative therapy, the value isn’t the label alone. The value is that every part of the system, from lab handling to patient selection, can be designed around that model.
Good regenerative medicine doesn’t begin with “What sounds appealing?” It begins with “What biology gives this patient the strongest and most reliable starting point?”
That is often the decisive shift for patients asking whether their own older cells are automatically the better choice. Sometimes they aren’t.
Patient Questions on Cell Therapy Answered
Are donor cells automatically riskier than my own cells
They carry different considerations, not a simple good-versus-bad verdict. Your own cells are naturally familiar to your immune system, which is one reason autologous therapy is often perceived as safer in principle. Donor cells require more attention to sourcing, processing, and clinical context.
In regenerative medicine, that’s why the discussion has to move beyond labels. The cell type, preparation standards, and treatment design all matter.
If I’m older, are my own cells weaker
That can be a real concern. As people age, the body’s regenerative reserve may change, and chronic inflammation or illness can influence the quality of the source material. This doesn’t mean your cells have no therapeutic value. It means “my own cells” and “my best cells” may not always be identical ideas.
That question is one of the main reasons many patients explore allogeneic options.
Does using donor cells mean I’ll get graft-versus-host disease
Not every donor-based regenerative treatment carries the same risk profile as transplant oncology. GVHD is a major concern in certain transplantation settings, which is why those data are so important. But regenerative medicine typically involves different goals, different cell types, and different treatment designs.
The right takeaway isn’t to ignore immune risk. It’s to ask whether the clinic can explain why its chosen cell type and lab process are appropriate for regenerative use.
How do I know whether a clinic takes safety seriously
Ask concrete questions. A credible clinic should be able to explain donor screening, lab processing, documentation, product traceability, and physician oversight in plain language. If the answers stay vague, that’s a concern.
Useful questions include:
- What cell source is being used
- How are donors screened
- Is the processing handled in-house or outsourced
- What quality control steps happen before treatment
- Who provides medical oversight
Why do some clinics use different donor cell sources
Because different tissue sources may have different clinical roles. An advanced regenerative program doesn’t treat all donor-derived cells as interchangeable. Source selection should reflect treatment goals, physician judgment, and lab capability.
That’s one reason source transparency matters so much.
Why do so many US and Canadian patients consider treatment in Mexico
Patients often look to Mexico because some clinics there offer integrated regenerative care, advanced diagnostics, and in-house biologic processing in a more efficient setting. But the country itself is not the credential. The important issue is whether the specific clinic demonstrates real medical oversight, transparent standards, and a lab process that can be explained clearly.
What’s the smartest way to approach a consultation
Go in with goals, not just hope. Be ready to discuss your diagnosis, symptoms, prior treatments, medications, imaging, and timeline. Ask the clinic to explain why a specific cell source is being recommended for your case.
A useful consultation should leave you feeling more informed, not more dazzled.
Author and Medical Review
Author
Dr. Kirk Sanford, DC. Founder & CEO, Longevity Medical Institute. Dr. Sanford focuses on patient education in regenerative and longevity medicine, translating complex therapies into clear, practical guidance for patients.
Medical Review
Dr. Félix Porras, MD. Medical Director, Longevity Medical Institute. Dr. Porras provides clinical oversight and medical review to help ensure accuracy, safety context, and alignment with current standards of care.
Last Reviewed: April 21, 2026
Short Disclaimer
This information is for educational purposes only and is not medical advice. It does not replace an evaluation by a qualified healthcare professional. For personalized guidance, please schedule a consultation.
If you’re considering donor-based regenerative care for joint pain, inflammation, recovery, or healthy aging, Longevity Medical Institute offers physician-led evaluation, advanced diagnostics, and allogeneic cell therapy supported by an in-house biotechnology platform in San José del Cabo.